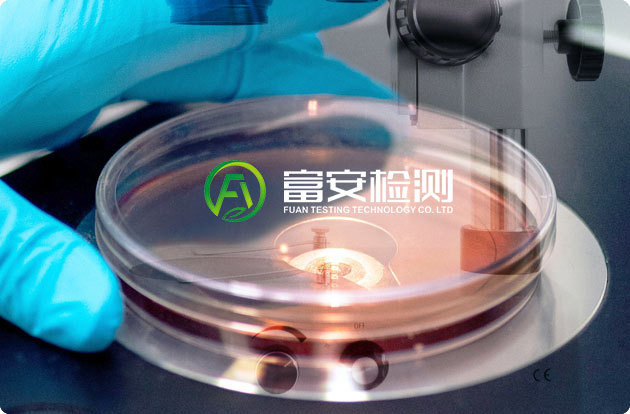

ABOUT FUAN
關(guān)于富安檢測(cè)
山東富安檢測(cè)技術(shù)有限公司于2021年9月成立,注冊(cè)地:濟(jì)南市長(zhǎng)清區(qū)創(chuàng)新谷九方創(chuàng)投基地2號(hào)樓三單元501,注冊(cè)資本500萬(wàn)元。實(shí)驗(yàn)室面積300平米,辦公面積200平米。公司設(shè)有檢測(cè)部、檢驗(yàn)部、評(píng)價(jià)部、質(zhì)量部、辦公室和市場(chǎng)部等部門(mén),現(xiàn)有各類(lèi)專(zhuān)業(yè)技術(shù)人員52人,其中高級(jí)職稱(chēng)7人,工程師15人,助理工程師20人,中級(jí)及以上技術(shù)職稱(chēng)或同等能力專(zhuān)業(yè)技術(shù)人員…

富安檢測(cè)
為客戶提供滿意的檢測(cè)結(jié)果

— 聯(lián)系熱線電話 —
0531-59568600
|
|